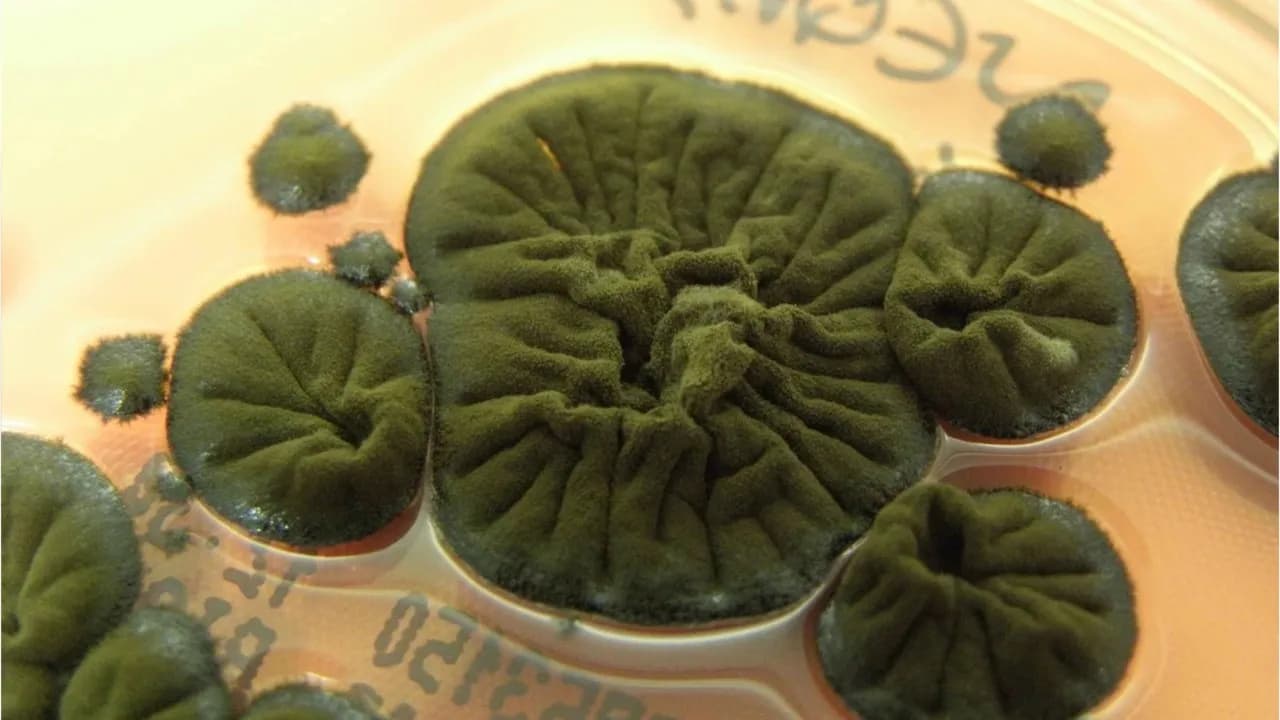

Geschichte der Nuklearkatastrophe
40 Jahre nach dem Super-GAU: Tschernobyl betrifft uns bis heute
Veröffentlicht:
von Marie-Finn Bruker:newstime
IAEA warnt: Tschernobyl-Hülle schwer beschädigt (6. Dezember 2025)
Videoclip • 01:20 Min • Ab 12
Die Nuklearkatastrophe im Atomkraftwerk Tschernobyl ereignete sich 1986 - doch die Folgen treffen auch 40 Jahre später noch Menschen in ganz Europa, der Ukraine, Deutschland. Wie aus einem einfachen Test eine weltbewegende Katastrophe wurde.
Das Wichtigste in Kürze
1986 kam es in Tschernobyl zur einer der größten nuklearen Katastrophen in der Geschichte der Atomenergie.
Die Auswirkungen reichen von den ersten Tagen nach dem Unfall bis heute.
Durch den Ukraine-Krieg wurde die Schutzkuppel im AKW Tschernobyl mehrmals beschädigt.
Es ist die Nacht zum 26. April 1986. Zwei in weiße Kittel gekleidete Männer stehen in der grell beleuchteten Zentrale in Block Nummer vier. Vor ihnen eine lange, kreisrunde Schaltkonsole, ihre bunten Schalter und Reglern ziehen sich durch den Raum.
Dann beginnen die Schalter zu flackern, Warnsignale tauchen die Zentrale in rotes Licht. "Reaktor drosseln!", schreit einer der Männer, der andere drückt den Notknopf.
Im selben Moment explodiert über einer Stadt in der Ukraine ein riesiger, orangeroter Feuerball. Seine radioaktiven Strahlen sind das Todesurteil Tausender Menschen. Es gibt Hunderttausend Verletzte, Zehntausende werden zwangsumgesiedelt.
Die Reaktorkatastrophe von Tschernobyl ist einer der größten Unfälle in der Geschichte der Atomenergie. Ihre Folgen betreffen uns auch 40 Jahre nach dem Unglück noch.
Auch in den News:
Wie ein Routinetest zum Super-GAU führte
Das Herzstück eines Kernkraftwerks ist der Reaktor. Sein Inneres muss kontinuierlich gekühlt werden, um die Kernschmelze zu verhindern. Auch im Falle eines Stromausfalls.
Für den Nachweis einer funktionierenden Kühlung auch ohne Energiezufuhr muss ein Stromausfall simuliert werden. Eine reine Routinen-Sicherheitsmaßnahme, die in besagter Aprilnacht vom diensthabenden Schichtleiter Aleksandr Akimow und seinem 25-jährigen Kollegen Leonid Toptunow durchgeführt werden sollte. Die beiden machten bereits einige Überstunden, als der Testlauf gegen 1:23 Uhr (Ortszeit) startete.
Akimow begann also, langsam den Reaktor herunterzufahren. Dabei blieb sein Blick an dem Messgerät an der Wand haften. Die absteigenden Zahlen darauf lösten Unbehagen in dem Nukleartechniker aus. Die angegebene Leistung war bereits weit unter dem Grenzwert gefallen – dann stieg sie plötzlich rasend schnell an. Sofort wies Akimow seinen Kollegen an, den Reaktor zu drosseln. Doch es war bereits zu spät.
Vom Kontrollverlust zur Katastrophe
Es kam zur Kettenreaktion. Die regulierenden Steuerstäbe waren aufgrund der Hitze bereits verformt und eine Notabschaltung somit nicht mehr möglich. Nur Sekunden später zersprang der Reaktorkern durch die massenhaft freigesetzte Energie. Bei über 2.000 Grad setzte die Kernschmelze ein. Es folgten zwei Explosionen. Sie sprengten die tonnenschwere Abdeckplatte des Reaktorkerns und das Dach des Gebäudes.
Unmengen an radioaktiven Stoffen verteilten sich kilometerhoch in der Atmosphäre.
Der Bundeszentrale für politische Bildung (bpb) zufolge wurden rund 150.000 Quadratkilometer in der Ukraine, Belarus und Russland radioaktiv verseucht. Ostwinde trugen die strahlenbelastete Luft bis nach Europa.
Warum eigentlich "Super-GAU"?
Wenn man über die Katastrophe im AKW von Tschernobyl spricht, ist oft von einem "Super-GAU" die Rede. Die Buchstaben setzen sich aus "Größter Anzunehmender Unfall" innerhalb eines Kernkraftwerkes zusammen. Damit stellt ein Super-GAU die Steigerung einer Katastrophe dar: Ein Unfall, der noch größer ist, als zuvor für möglich gehalten.
In den 1990er-Jahren führte die Internationale Atomenergie-Organisation (IAEA) die "International Nuclear and Radiological Event Scale" (INES) ein. Sie reicht von 0 (Ereignis ohne oder mit geringer sicherheitstechnischer Bedeutung) bis 7 (katastrophaler Unfall). Bislang gelten Tschernobyl und Fukushima als die einzigen Katastrophen der INES-Stufe 7.
Die Liquidatoren von Tschernobyl
Direkt nach dem Unfall beorderte die sowjetische Regierung tausende Soldaten und Spezialgruppen zum Unfallort, um die austretenden Strahlungsmassen zu "liquiditieren". Damit ist laut bpb die Eindämmung der Folgen dieser Katastrophe gemeint. Das erwies sich als große Herausforderung: Noch zehn Tage nach dem Unglück spuckte der Reaktor heiße Asche und radioaktive Gase in die Luft. Insgesamt arbeiteten etwa 600.000 bis 800.000 Helfer:innen bis zu mehrere Monate an der Zuschüttung des brennenden Kernreaktors. Viele von ihnen ohne geeignete Schutzkleidung.
Und die sowjetische Bevölkerung? Die erfuhr lange nichts von den gravierenden Ausmaßen des Unfalls.
Vor Ort vertuscht, tausend Kilometer entfernt aufgedeckt
Bis zum Abend des 26. Aprils erklärte die Werksleitung von Tschernobyl Block 4 als intakt, er müsse lediglich gekühlt werden. Die sowjetische Bevölkerung erfuhr erst zwei Tage später, dass es überhaupt einen Unfall gegeben hatte. Wie gefährlich die Lage deshalb war, verschwieg die UdSSR-Regierung.
Über 1.200 Kilometer von Tschernobyl entfernt maßen schwedische Wissenschaftler:innen kaum 36 Stunden nach der Katastrophe eine erhöhte Radioaktivität. Schnell verdichtete sich der Verdacht Richtung Sowjetunion. Diese bestätigte erst am 29. April, dass es in Tschernobyl zu einem Unfall gekommen war.
Erst über einen Tag nach dem Unfall begann die Evakuierung der Menschen aus den umliegenden Städten, der sogenannten "Sperrzone". Die vollständige Umsiedlung aller dort lebenden Einwohner:innen dauerte bis zum 5. Mai.
Deutschland: Und dann kam der Regen
In den Folgetagen wehten Ostwinde die radioaktive Wolke aus Tschernobyl nach Westen. Tagelang fiel strahlenbelasteter Regen unterschiedlicher Intensität auch auf Deutschland. Das damals geteilte Land einte in diesen Tagen jedoch ein Gefühl: Ungewissheit.
"Die Meldungen aus den Nachrichtensendungen waren sehr vage, man hat sich die Informationen zusammenklauben müssen", erinnert sich Peter Köninger, Bezirkspräsident Mittelfranken des Bundesbauernverbands, im Interview mit :newstime. "Wir waren in tagelanger Unsicherheit. Man hat nur gewusst: In Tschernobyl ist was richtig Gewaltiges passiert."
Lange habe man nicht geahnt, wie groß das atomare Ausmaß des Unfalls in Deutschland war. Auch auf Köningers landwirtschaftlichem Betrieb fragte man sich: "Wie lange halten jetzt die Vorräte noch? Wie lange bleibt das, dass man von den landwirtschaftlichen Flächen nichts mehr einbringen darf?"
Viele Menschen der BRD blieben aus Angst vor der überall vermuteten Strahlung zu Hause. Einige horteten Lebensmittel in Konservendosen, bis die Ämter Nahrung wie Milchprodukte und frisches Gemüse offiziell als ungefährlich erklärten.
Die DDR erfuhr vor allem aus westlichen Quellen von den Dimensionen des Super-GAUs. Als "kleiner Bruder" der Sowjetunion hielt die Regierung in Ostdeutschland viele Informationen vor der Bevölkerung zurück.
Mit Tschernobyl habe sich die Einstellung der Deutschen zur Kernkraft zutiefst gewandelt, erklärt Köninger weiter. "Ab diesem Zeitpunkt war man ganz anders sensibilisiert", erinnert sich der Landwirt. "Das hat ganz bestimmt den Anfang in Tschernobyl. Davor hat keiner differenzierter über das Ausmaß und die Gefahren von Atomkraft nachgedacht."
Die Opfer von Tschernobyl
Die Akutphase der radioaktiven Belastung nach dem Super-GAU umfasste dem Deutschen Ärzteblatt zufolge mehrere Wochen. Doch die Langzeitfolgen belasten seit Jahrzehnten.
Bis heute gibt es keine genauen Zahlen aller infolge der Nuklearkatastrophe belasteten Personen. Die weltweite Organisation von Gesundheitsfachkräften "Internationale Ärzte für die Verhütung des Atomkrieges – Ärzte in sozialer Verantwortung" (ippnw) setzt sich für die Abschaffung von Atomwaffen und Atomenergie ein. Sie geht allein unter den damaligen Direkthelfer:innen von 125.000 Erkrankten aus. Rund 600.000 Menschen aus dem mehr als 4.000 Quadratkilometer großen Sperrgebiet sollen mehrere Tage einer schweren Strahlenbelastung ausgesetzt gewesen sein.
Auch Menschen in Europa litten unter Folgeerscheinungen. Betroffen waren vor allem Schwangere und Kinder. Tausende Menschen starben infolge einer durch die Strahlung verursachten Krebs- oder Schilddrüsenerkrankung. Viele weitere litten nach dem Unfall unter psychischen Belastungen, die in einigen Fällen zu Suizid führten.
Schutzhülle im Ukrainekrieg beschädigt
Um die Strahlung des Reaktors langfristig einzudämmen, wurde 1986 ein "Sarkophag" aus Stahl und Beton errichtet. Mit der Zeit wurde der Bau marode. Bis 2016 arbeitete man an einer neuen Schutzhülle, einer gigantische Stahlkonstruktion. Unter dem alten Sarkophag sollen laut Bundesministerium für Umwelt, Naturschutz, nukleare Sicherheit und Verbraucherschutz (BMUV) 440.000 Kubikmeter Atomabfälle gelegen haben.
Infolge des russischen Angriffskriegs gegen die Ukraine wurde die Kuppel mehrmals beschädigt.
Mit Beginn des Krieges Anfang 2022 wurde die Sperrzone um Tschernobyl zunächst von russischen Einheiten eingenommen. Später wurde der Bereich wieder an ukrainisches Personal übergeben.
Nach Angaben des ukrainischen Präsidenten Wolodymyr Selenskyj beschädigte eine russische Drohne vergangenes Jahr die Schutzhülle des beschädigten Atomkraftwerks. Durch den Angriff verlor sie ihre primären Schutzfunktionen, zunächst wurden aber keine erhöhten Strahlenwerte gemeldet.
Im Oktober 2025 kam es erneut zu einem russischen Luftangriff auf Tschernobyl. Zeitweise fiel rund um den zerstörten Reaktorblock der Strom aus, sowie erneut zu Beginn des Jahres 2026.
40 Jahre später: Hier strahlt es noch in Deutschland
Die Folgen des Super-GAUs erstrecken sich über Jahrzehnte, auch heute wird regelmäßig die Strahlenbelastung gemessen. Besonders Pilze und Wildschweine sind teilweise noch kontaminiert. Allein in Sachsen wurden vergangenes Jahr bei 109 Wildschweinen Strahlenwerte über der zulässigen Grenze festgestellt. Die Tiere essen besonders strahlungsanfällige Pilzsorten, die für Menschen jedoch ungenießbar sind.
Pilzsammler:innen müssen sich also keine Sorgen machen: Bislang gibt es keine neueren Berichte über verseuchte essbare Pilze, die die Zulassungsgrenze überschreiten.
Auch der Leiter des BfS-Fachgebiets Radioökologie, Martin Steiner, gibt Entwarnung: In Deutschland sei die durch den Unfall verursachte zusätzliche Strahlenbelastung gering. Gesundheitliche Auswirkungen müssten nicht befürchtet werden.
Verwendete Quellen:
Nachrichtenagentur dpa
Bundeszentrale für politische Bildung (bpb): "Dossier Tschernobyl"
Internationale Ärzte für die Verhütung des Atomkrieges – Ärzte in sozialer Verantwortung (IPPNW): "30 Jahre Leben mit Tschernobyl 5 Jahre Leben mit Fukushima"
Bundesministerium für Umwelt, Naturschutz, nukleare Sicherheit und Verbraucherschutz (BMUV): "Tschernobyl und die Folgen"
Landeszentrale für politische Bildung Baden-Württemberg (lpb): "Die Atomkatastrophe von Tschernobyl"
:newstime verpasst? Hier aktuelle Folge ansehen
Mehr entdecken

Mitarbeiter in Ungewissheit
Meta plant Entlassungswelle – aber investiert massiv in KI

Softwareunternehmen
SAP wächst dank Cloud – doch der große Schub soll erst noch kommen

Weniger Essen
Schluss mit Döner-Posts: Söder ändert Strategie auf Social Media

Rücksichtsvolles Reisen
Schweiz startet Benimm-Kampagne für Touristen

Porträt
Walter Gunz – Warum finanziert er Timmys Rettung?

Schleuste Gewinn ins Ausland
Er wettete mit Geheimwissen auf Absetzung von Maduro: US-Soldat vor Gericht